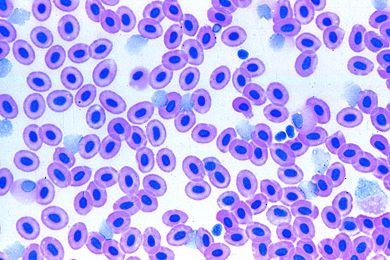
Mikropräparat - Cyprinus, Blutausstrich

Pisces - Fische, Teleostei (Knochenfische), Einzelpräparat - Unsere Mikropräparate werden unter wissenschaftlicher Leitung hergestellt. Sachgemäß fixiertes und konserviertes Ausgangsmaterial ist die Voraussetzung für einwandfreie Präparate. Wir verwenden deshalb auf diese Arbeitsgänge besondere Sorgfalt.
Die Herstellung der Mikrotomschnitte erfolgt durch erfahrene Fachkräfte, Schneidetechnik und Schnittdicke werden den Objekten angepaßt. Aus der großen Zahl der in der Mikroskopie üblichen Färbemethoden wählen wir solche, die eine klare und kontrastreiche Darstellung der gewünschten Strukturen mit bester Haltbarkeit verbinden. Meist handelt es sich dabei um Mehrfachfärbungen. Alle Präparate können einzeln bezogen werden.
Verschiedene Präparate bereiten von der Beschaffung und Verarbeitung des Ausgangsmaterials her besondere Schwierigkeiten und können deshalb oft nur mit längerer Lieferzeit hergestellt werden.
Zubehör: - Präparatekasten aus Kunststoff für 25 Präparate - wird bei Ihrer Bestellung automatisch mit geliefert und separat berechnet.
Verifizierter Kauf *
Geschrieben von verifizierten Kunden am 15.06.2016
Meine Erfahrung: empfehlenswert!
Eine Bereichung für meinen Arbeitsalltag
Verifizierter Kauf *
Geschrieben von Udo S. am 20.12.2012
Bin hier Zufrieden
Hat soweit ganz gut geklappt.Gute Ware
Verifizierter Kauf *
Geschrieben von verifizierten Kunden am 26.01.2012
sehr Informativ
bei genauem Hinsehen, findet man viele interesante sa
Herstellerkennzeichnung
Herstellerkennzeichnung
Name: Johannes Lieder GmbH & Co. KGPostleitzahl: Ludwigsburg
Telefonnummer: +49 7141 921919